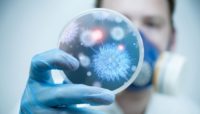
НОВИЙ КОРОНАВІРУС: ШЛЯХИ ПЕРЕДАВАННЯ І ВАРІАНТИ ЗАХИСТУ

Щорічно 25 травня відзначається Всесвітній день щитоподібної залози (World Thyroid Day). Дата увійшла в календар у 2009 році з ініціативи Європейської тироїдної асоціації. Щитоподібна залоза виробляє гормони, які беруть участь у регуляції низки біохімічних процесів, у тому числі адаптації інтенсивності […]

Що варто знати про COVID-19
Як передається вірус SARS-CoV-2 (збудник COVID-19)? Вірус передається від людини до людини краплинним та контактним шляхами. Тобто через дрібні часточки, які виділяються з носа або рота хворого на COVID-19 під час кашлю або чхання. Ці краплі розповсюджуються на відстань близько […]

Оновлена інформація щодо тимчасових змін правил ввезення медичних виробів
16 квітня набула чинності постанова Кабінету Міністрів України від 08.04.2020 № 271 «Про внесення змін до деяких постанов Кабінету Міністрів України», якою змінено правила введення в обіг та/або експлуатацію медичних виробів / активних медичних виробів, які імплантують / медичних виробів для […]

Онлайн-платформа «Дія. Цифрова освіта» запустила курс навчання для державних службовців
Міністерство цифрової політики України запустило національну онлайн-платформу з цифрової грамотності «Дія. Цифрова освіта», як доступна за посиланням. Кожний громадянин може безкоштовно опанувати цифрові навички за сучасним форматом – освітні серіали. Наразі на онлайн-платформі доступна програма «Цифрова грамотність державних службовців» на базі інструментів Google. […]

Рекомендації для осіб, з підозрою або хворими на COVID-19, які перебувають вдома на самоізоляції
Залишайтеся вдома за винятком необхідності медичної допомоги Ви повинні обмежувати діяльність поза своїм будинком/квартирою, за винятком отримання медичної допомоги. Не ходіть на роботу, до школи чи громадські приміщення. Не користуйтесь громадським транспортом або таксі. Відокремте себе від інших людей і […]

Що таке новий коронавірус SARS-CoV-2 (2019-nCoV)?
Новий коронавірус 2019 року (SARS-CoV-2, або 2019-nCoV) — це новий вірус, який спричиняє розвиток респіраторних захворювань у людей (зокрема гострої респіраторної хвороби COVID-19) та може передаватися від людини до людини. Цей вірус уперше був ідентифікований під час розслідування спалаху в […]

Як бути активними та здоровими взимку
З настанням холодів багато людей стають менш активними та відмовляються від прогулянок надворі та спортивних навантажень. Звичайно, це негативно впливає на здоров’я. Більшість сезонних захворювань у зимовий період виникає не через надмірне перебування на холоді. Погано провітрені приміщення, сухе повітря […]
НОВИЙ КОРОНАВІРУС: ШЛЯХИ ПЕРЕДАВАННЯ І ВАРІАНТИ ЗАХИСТУ
Наразі відомо, що новий коронавірус передається краплинним та контактним шляхами. Переважає контактний шлях, коли вірус потрапляє на слизові оболонки носа, очей через руки або інші предмети (хустинку, рукавиці) після торкання до об’єктів (тварин, м’яса, риби, дверних ручок, поручнів), що контаміновані (забруднені) виділеннями […]

Вакцинація: від яких хвороб варто захиститись
Вакцинація щороку рятує 2-3 мільйони людей у всьому світі від небезпечних хвороб та запобігає 1,5 мільйонам летальних випадків від інфекційних хвороб. В Україні Календар профілактичних щеплень передбачає вакцинацію проти 10 захворювань: туберкульозу, поліомієліту, дифтерії, кашлюка, правця, кору, гепатиту В, гемофільної інфекції, краснухи, епідемічного […]

